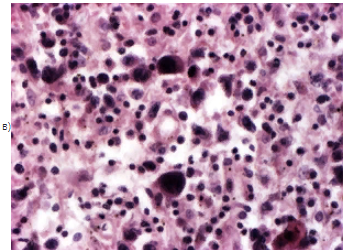

Материал: Лекция 12 (Опухоли кроветворной и лимфоидной ткани)
3. Смешанно-клеточный - равное соотношение опухолевых и неопухолевых клеток, больные живут до 4.5-5 лет.
4. С подавлением лимфоидной ткани, много клеток Р-Б-Ш или склеротические изменения, смерть в течении 1.5 лет.
В некоторых случаях может наблюдаться переход одной формы ЛГМ в другую. Более доброкачественное течение у женщин.
Причины смерти больных ЛГМ:
1. Интоксикация
2. Анемия
3. Общий амилоидоз
4. Присоединение вторичной инфекции
5. Присоединение туберкулеза.

Лимфогранулематоз печени. а) ×10, б) ×60
Лимфогранулематоз,
вариант нодулярного склероза: стертость
структуры лимфоузла, склероз, б) и в) –
полиморфноклеточный инфильтрат с
клетками Ходжкина и Рид-Березовского-Штернберга.
а) ×35, б) ×100, в) ×200
Лимфогранулематоз,
вариант нодулярного склероза: стертость
структуры лимфоузла, склероз, б) и в) –
полиморфноклеточный инфильтрат с
клетками Ходжкина и Рид-Березовского-Штернберга.
а) ×35, б) ×100, в) ×200